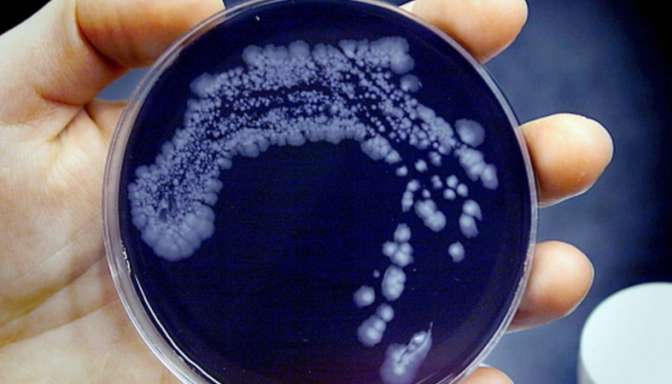

Эрдоган рассказал о беседе с Путиным про сирийских туркменов

Президент Турции Реджеп Тайип Эрдоган утверждает, что говорил с русским лидером Владимиром Путиным о сирийских туркменах, проживающих в районах бомбардировок на севере Сирии, хотя сам Путин недавно заявлял, что про них «слыхом не слыхивал». Как сообщает Vesti.az ссылаясь на РИА Новости, об этом Эрдоган проинформировал выступая на собрании Торгово-промышленной палаты в Бурсе.
«Я верю, что наш экспорт снова будет увеличиваться».
До этого на ежегодной пресс-конференции президент Владимир Путин в процессе ежегодной пресс-конференции 17 декабря объявил, что о так называемых туркоманах на севере Сирии он ничего не знал.
Сравнительный анализ уровня цен и социальных выплат 2-х стран — Турции и РФ — показывает, как живут жители 2-х однажды дружных государств, и какой удар может нанести агрессивная политика турецкой власти размеренной жизни народа. «Вы можете не волноваться», — проинформировал Эрдоган турецким предпринимателям. Как до этого докладывало a-evmenov.ru, 24 ноября ВВС Турции сбили русский бомбардировщик Су-24, участвовавший в боевой операции против террористической организации «Исламское государство». Командир экипажа умер, штурман был спасен.

Следите за новостями в Telegram
👇 Поделитесь в вашей соцсети